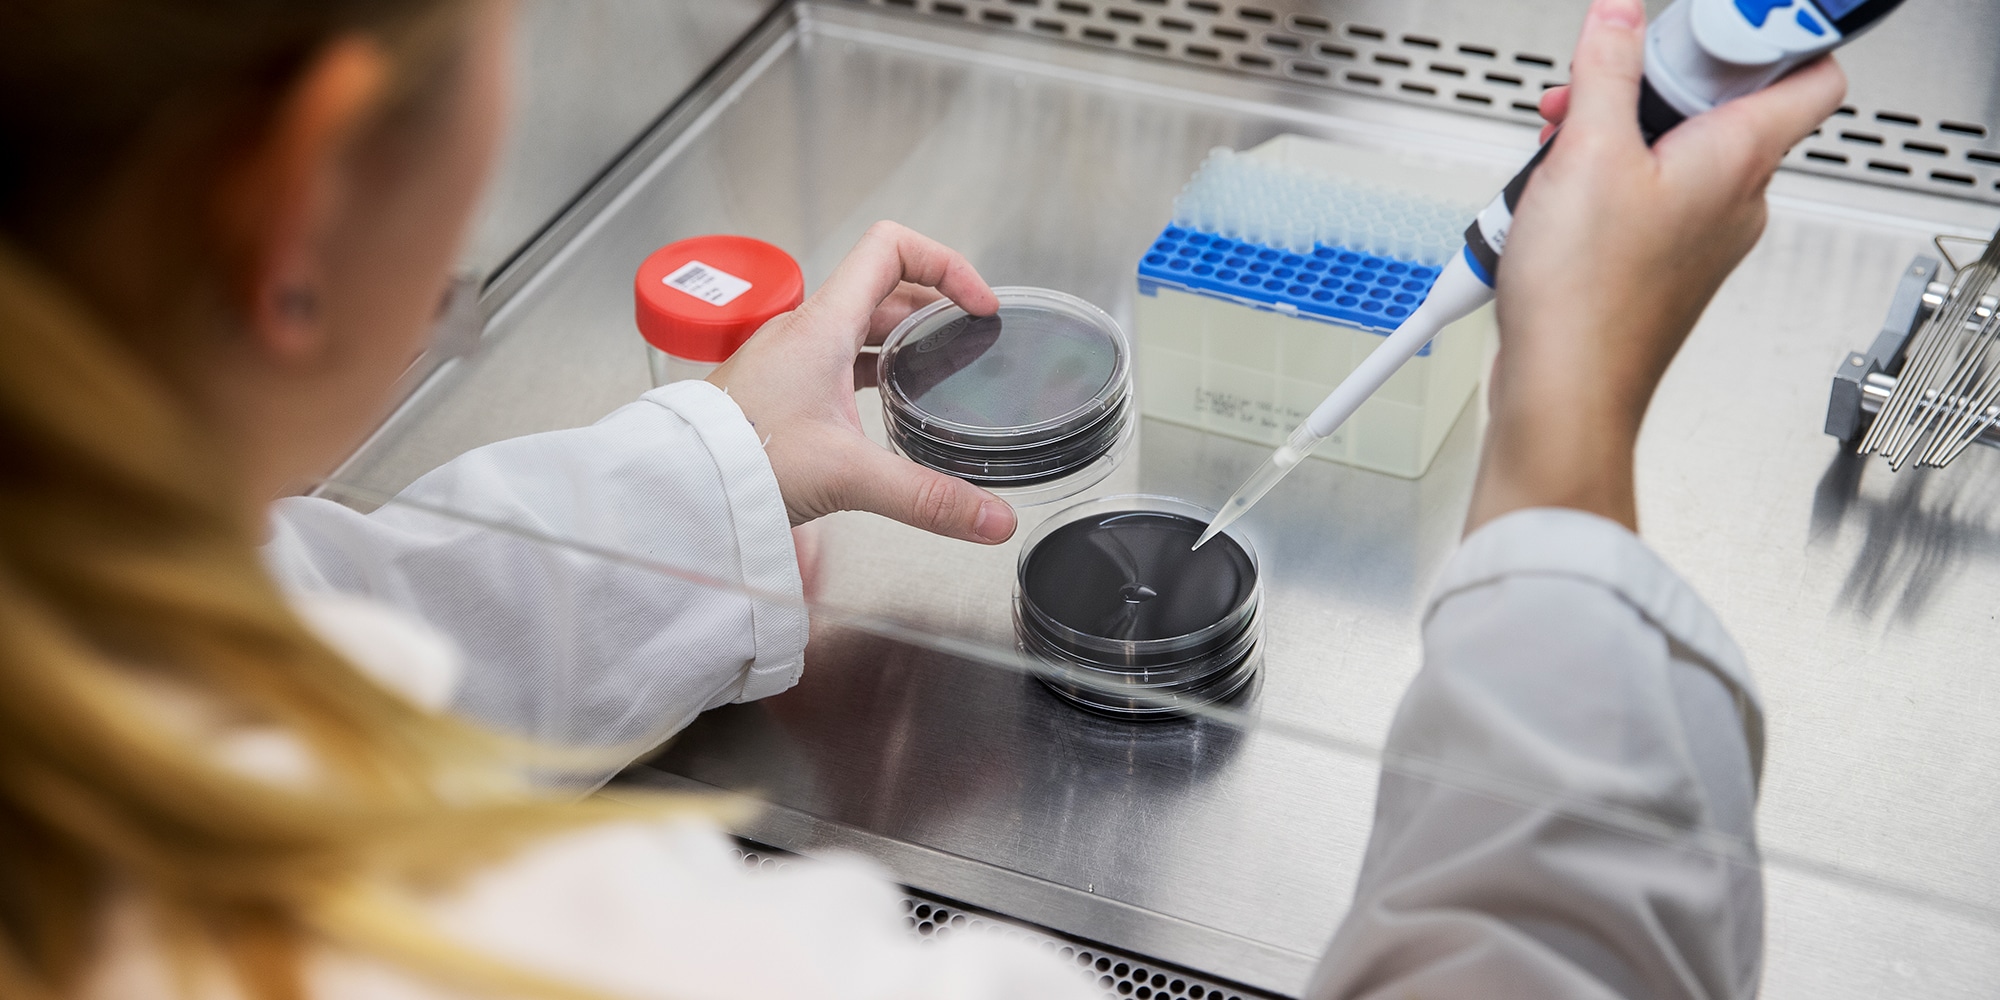
Legionella-onderzoek

Legionella onderzoek
| Neaped
Wie werkt met proces- en drinkwaterinstallaties, moet ook veel aandacht besteden aan legionella onderzoek. Het is namelijk van groot belang dat er geen legionella in het water zit, dat zich vervolgens kan verspreiden en mensen ziek kan maken. AQ Group helpt bij legionella onderzoek. Wij zijn BRL gecertificeerd en voldoen hiermee aan alle wettelijke eisen.
Legionella-onderzoek
| Legionella-onderzoek | Normec AWS | legionella dodelijk | Legionella, zin en onzin bij labo-onderzoek | LaboNuytinck |
|---|---|---|
| Legionella Onderzoek | Monstername, Analyse en Advies | legionella symptomen incubatietijd | legionella zelftest |
| Legionella onderzoek - Micro-Analyse Zeeland | legionella test | herstel na longontsteking legionella |
| legionella verschijnselen: Wij zijn een kennisbron op het gebied van Legionella-onderzoek. | ||

legionella besmetting vaststellen
Ja, de legionella onderzoeken zijn geaccrediteerd. Op het analysecertificaat is deze dan gemerkt met een Q. Ja, monstername ten behoeve van legionella onderzoek van drinkwater, zwemwater en proceswater is geaccrediteerd. Voor nadere informatie, of voor het aanvragen van de noodzakelijke monsterflessen, kunt u contact met ons opnemen via het "contactformulier".
